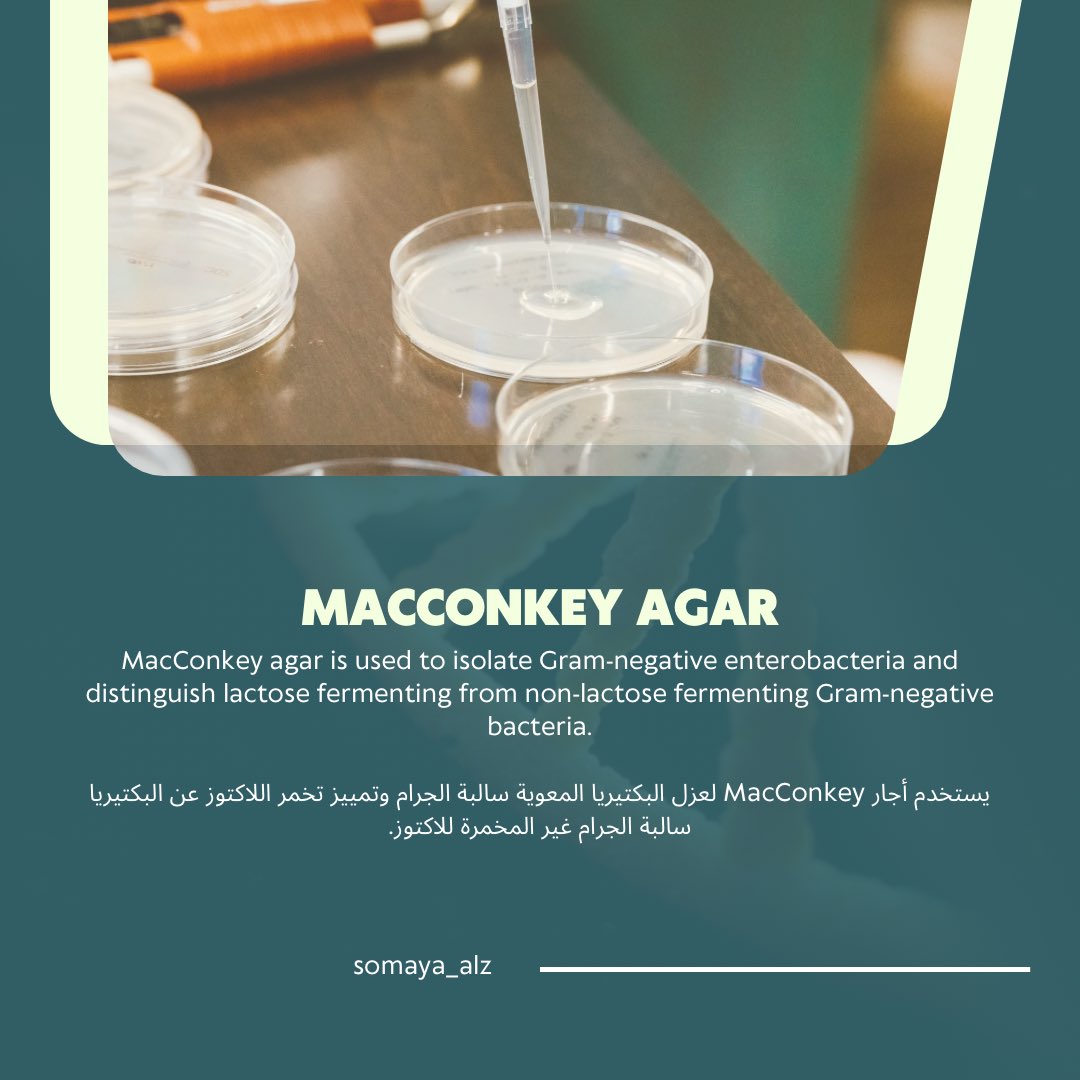
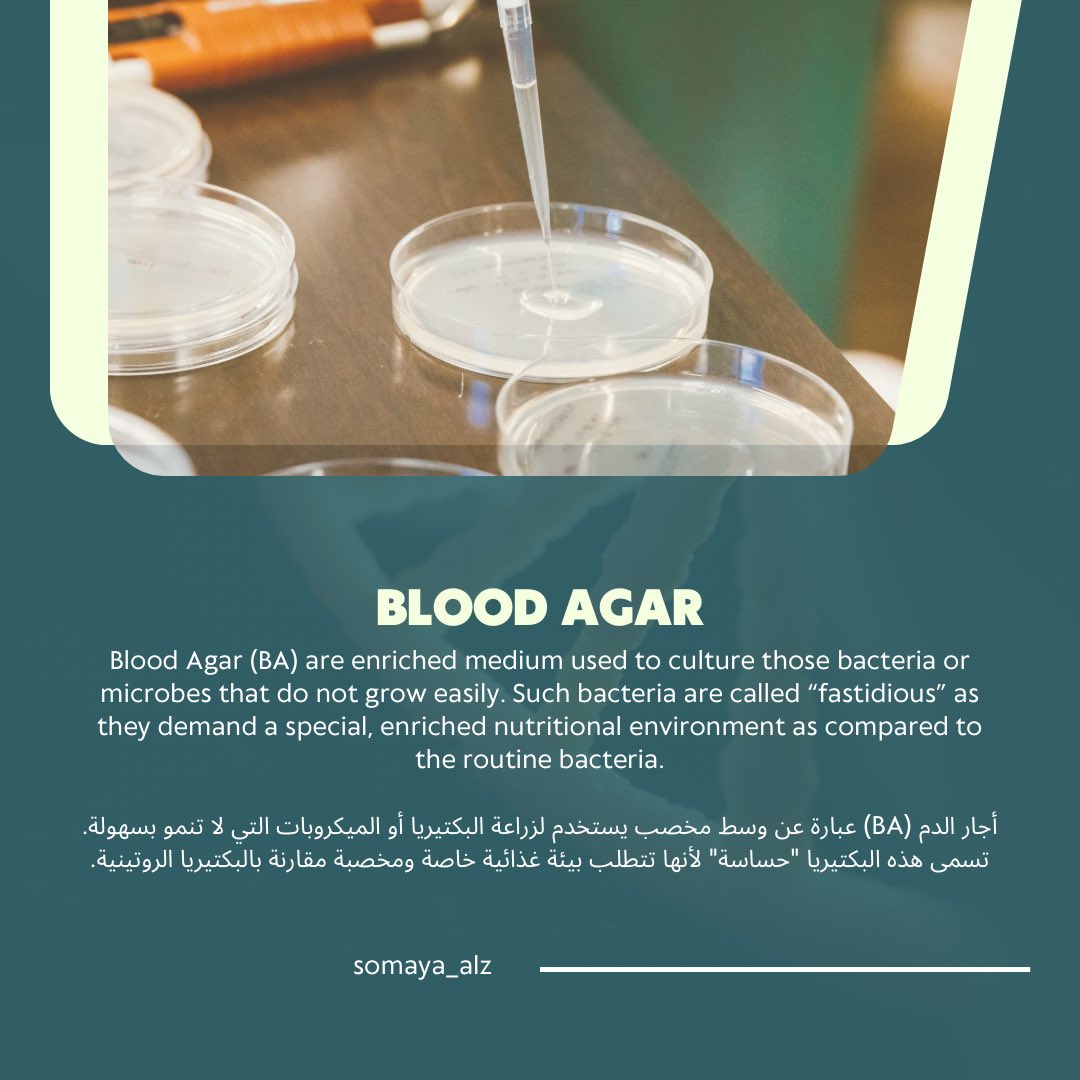
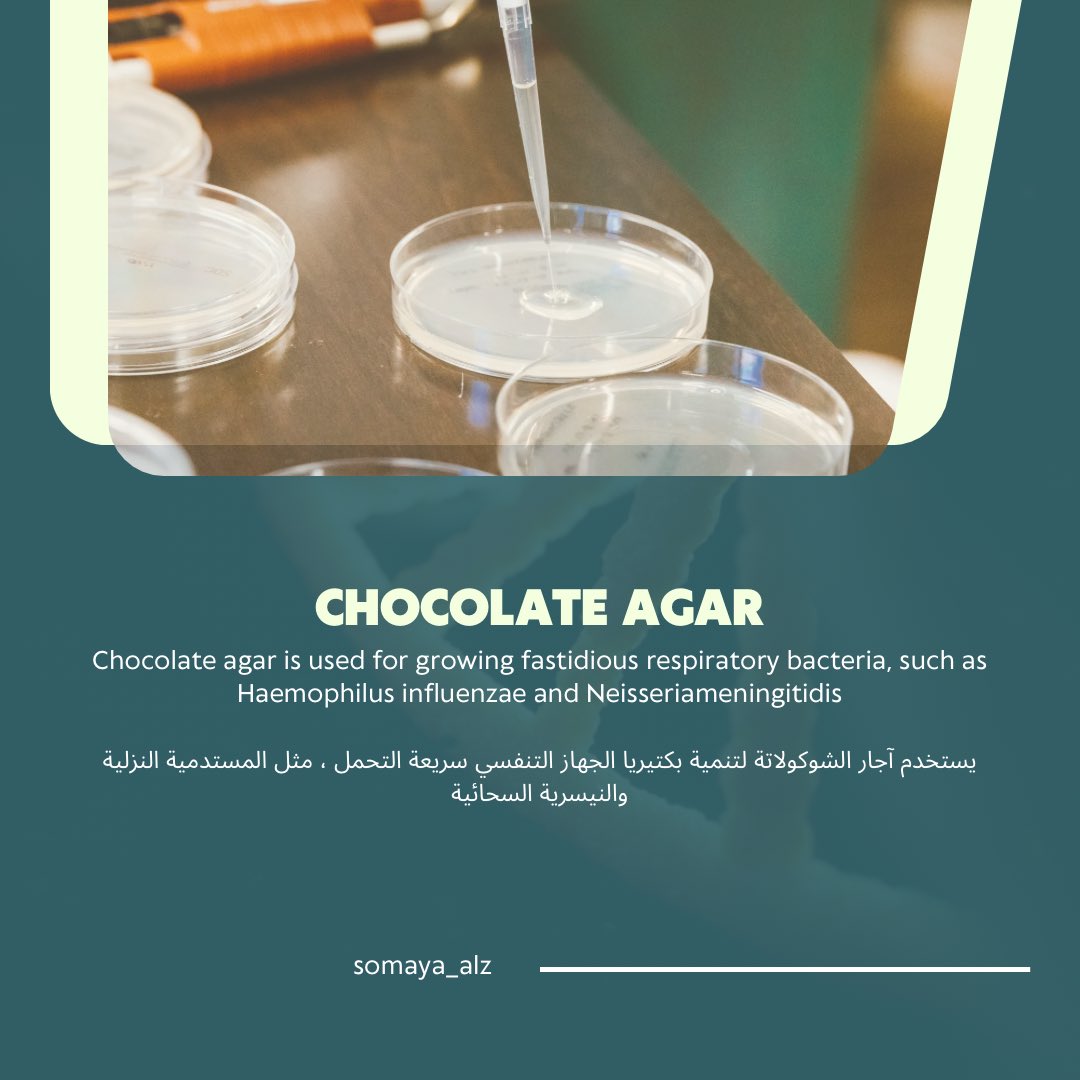

#ثريد #المختبرات
٢٥-شعبان-١٤٤٤هـ
التدريب الميداني " مستشفى السعودي الألماني 🏥 "
🔻حشاركم بأذن الله بنبذة بسيطة عن الأقسام اللي حغطيها داخل المختبر
٢٥-شعبان-١٤٤٤هـ
التدريب الميداني " مستشفى السعودي الألماني 🏥 "
🔻حشاركم بأذن الله بنبذة بسيطة عن الأقسام اللي حغطيها داخل المختبر
الوحدة الأولى ( Microbiology 🧫)
أقسامها :
1- Parasitology
2- Microbiology
3- Histology
4- Cytology
أقسامها :
1- Parasitology
2- Microbiology
3- Histology
4- Cytology
🔻المواد المهمة التي يجب مراجعتها قبل الدخول للقسم:
⁃ Micro , lab biology , Bioreactor
⁃ Micro , lab biology , Bioreactor
🔹بهذا القسم ماقدرت اشتغل بحكم حساسية الشغل فيه لكن ححاول اعطيكم ابرز الاجهزة اللي شفتها و بعض المعلومات اللي تعتبر مهمة 🔽
أهم الاجهزة داخل هذا القسم 🔽
- Incubator Co2
- Versatraek
- Incubator Co2
- Versatraek
🔹 Versatraek
youtu.be
youtu.be
Chemistry section 🤍🔽
🔹لاب الكيمستري
من اللابات اللي استمتعت فيها حرفيًا و انبسطت وانا اشتغل فيها 🤍🤍
▪️المواد المهمة التي يجب مراجعتها قبل الدخول للقسم:
⁃blood and fluids
من اللابات اللي استمتعت فيها حرفيًا و انبسطت وانا اشتغل فيها 🤍🤍
▪️المواد المهمة التي يجب مراجعتها قبل الدخول للقسم:
⁃blood and fluids
🔺ملاحظة مهمة
في هذا الاب بذات يحتاج الشخص يكون ملم اكثر بمجال المختبرات و طرق التعامل مع العينات و خاصة لو كان تخصصه كيمياء حيوية او مايكرو ..
في هذا الاب بذات يحتاج الشخص يكون ملم اكثر بمجال المختبرات و طرق التعامل مع العينات و خاصة لو كان تخصصه كيمياء حيوية او مايكرو ..
أهم الأجهزة المستخدمة 🔽
" Alinity hq “
" Alinity hq “
🔴على حسب ماسمعت من الستاف انو اجهزة Alinity شركة تصنيعها Apple ..
لما بحثت آكثر عن الموضوع ماحصلت شي بحد ذاته يدل انو شركة آبل المصنعة.🤔
لما بحثت آكثر عن الموضوع ماحصلت شي بحد ذاته يدل انو شركة آبل المصنعة.🤔
أهم الأجهزة المستخدمة 🔽
" Alinity ci "
يعتبر جهازين في جهاز واحد ، وينقسم الجهاز لجزء خاص بتحاليل قسم الكيمستري و جزء خاص بتحاليل قسم الهرمون .
قسم الكيمستري يرمز ( C )
قسم الهرمون يرمز ( i )
" Alinity ci "
يعتبر جهازين في جهاز واحد ، وينقسم الجهاز لجزء خاص بتحاليل قسم الكيمستري و جزء خاص بتحاليل قسم الهرمون .
قسم الكيمستري يرمز ( C )
قسم الهرمون يرمز ( i )
طريقة عمل الجهاز 🔽
youtu.be
youtu.be
🔸Hormone section
للاسف انو الوقت مااسعفني أدخل هذا القسم و استفيد من المعلومات اللي فيه ، لكن بإذن الله القادم أجمل 👍🏻😁
للاسف انو الوقت مااسعفني أدخل هذا القسم و استفيد من المعلومات اللي فيه ، لكن بإذن الله القادم أجمل 👍🏻😁
24 March 2023 , Friday
انتهى..
انتهى..
جاري تحميل الاقتراحات...